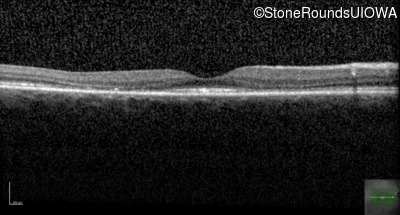
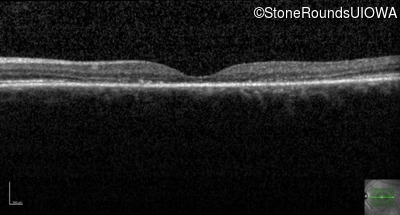

Case
SR964
Student Mode
Cone and Cone Rod Dystrophy (IA1b)
Female
Female
Hidden
SR964
Student Mode
Cone and Cone Rod Dystrophy (IA1b)
Female
Female
History
This 49 year old woman first experienced some loss of central vision in her left eye at age 44.
Diagnosis & molecular findings
| Disease | Gene | Allele 1 variant(s) | Allele 2 variant(s) | Inheritance mode |
|---|---|---|---|---|
| Cone and Cone Rod Dystrophy | CRX | Tyr221 del1cccT | AD |